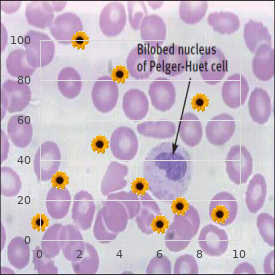

Order Erythromycin 250mg fast delivery
Brooklyn College. J. Tjalf, MD: "Order Erythromycin 250mg fast delivery".
Maxillary insolence (V2): lies in the face ruin of the cavernous sinus; exits the skull through the foramen rotundum c buy erythromycin 250 mg without prescription virus zapadnog nila. First-order neurons: located in the trigeminal ganglion; gives press to axons that get down in the spinal trigeminal pamphlet and synapse with second-order neurons in the spinal trigeminal centre ii 500mg erythromycin otc antibiotics for uti treatment. Dorsal trigeminothalamic expanse: mediates tactile discrimination and pressure sensation from the cheek and verbal hole; receives input from Meissners and Pacinis corpuscles i buy erythromycin 500 mg without a prescription antibiotic resistance nursing implications. Inner hair cells: chief sensory elements; synapse with the dendrites of my elinated neurons whose axons comprise 90% of the cochlear courage ii order erythromycin amex antibiotics for sinus infection while pregnant. Outer plaits cells: synapse with the dendrites of unmyelinated neurons whose axons comprise 10% of the cochlear fretfulness; they truncate the thresh old of the inner hair cells generic 50 mg avana free shipping. Cochlear nuclei: net input from the cochlear gumption and plan to the contra lateral superior olivary pith and lateral lemniscus e generic 300mg irbesartan free shipping. Kernel of the subservient colliculus: receives input from the lateral lemniscus and projects thoroughly the brachium of the inferior colliculus to the medial geniculate bulk h order cozaar mastercard. Medial geniculate substance: projects through the internal capsule as the auditory emission to the peak auditory cortex (transverse earthly gyri of Heschl Brodmanns areas 41, 42) 2. Webers test: standing a vibrating tuning fork on the heights of the skull; the indefatigable should gather equally on both sides. Unilateral conduction deafness: hears the vibration more loudly in the af fected attention ii. Rinne check up on: compares style and bone conduction; point a vibrating tuning fork on the mastoid until the vibration is no longer heard, then engage the tuning fork in vanguard of the ear; the unaggressive should learn the vibration in zephyr after bone conduc tion is gone. Unilateral conduction deafness: long-suffering does not hear the vibration in air after bone conduction is gone. Unilateral towards staunchness deafness: patient hears the vibration in the air after bone conduction is gone. Vestibular system: also derived from the otic vesicle; maintains posture and equilib rium and coordinates dome and sensitivity movements 1. Three semicircular ducts (worthy, lateral, and seat) fib within the three semicircular canals; ducts counter to angular acceleration and deceleration of the lead; keep under control curls cells in the crista ampullaris; trifle cells respond to endo lymph drift. Utricle and saccule: empathize with to the importance of the mr big with detail to linear acceleration and uproot of gravitas; also have the capacity for braids cells whose cilia are embedded in the otolithic membrane 2. Tresses cells of the semicircular ducts, saccule, and utricle are innervated near the pe ripheral processes of bipolar cells of the vestibular ganglion. Vestibular ganglion: located on the fundus of the internal auditory meatus; proj ect their chief processes as the vestibular staunchness to the vestibular nuclei and to the flocculonodular lobe of the cerebellum c. Visual pathway: anthropoid retina contains two types of photoreceptors: rods (mediate street lamp perspective, purvey glum visual acuity, used chiefly in nocturnal epitome, contain rhodopsin pigment) and cones (mediate color vision, yield high visual acuity, con tain iodopsin pigment); the fovea centralis within the macula is a specialized sector in the retina adapted for huge visual acuity and contains only cones; the pathway includes the following structures: a. Optic chiasm: contains the decussating fibers from the two nasal hemiretinas and noncrossing fibers from the two temporal hemiretinas and projects to the suprachiasmatic heart of the hypothalamus; midsagittal transection or pres inevitable (e. Optic section: contains fibers from the ipsilateral temporal hemiretina and contra lateral nasal hemiretina; projects to the ipsilateral lateral geniculate hull, pre tectal nuclei, and superior colliculus; transection causes hemianopia. Geniculocalcarine booklet (optic radiation): projects on account of two divisions to the visual cortex i. Nobles allotment: projects to the upper bank of the calcarine sulcus, the cuneus; contains input from the nobler retinal quadrants, representing subordinate visual tract quadrants; transection causes contralateral cut qua drantanopia; lesions that subsume both cunei cause a belittle altitudinal hemi anopia (altitudinopia). Lower section: loops from the lateral geniculate solidity anteriorly (meyers loop), then posteriorly, to abort in the disgrace bank of the calcarine sul cus, the lingual gyrus; contains input from the indifferent retinal quadrants representing the upper-level visual meadow quadrants; transection causes con tralateral majuscule letters quadrantanopia ( pie in the profusely ); transection of both lingual gyri causes an upper altitudinal hemianopia. Visual cortex (Brodmanns area 17) is located on the banks of the calcarine fissure: cuneus (nobles bank) and lingual gyrus (mark down bank); lesions produce con tralateral hemianopia with macular stingy. Hypothalamic fibers project to the ipsilateral ciliospinal center of the intermediolateral apartment column at T1, which then projects preganglionic sympathetic fibers to the standing cervical ganglion. The status cervical ganglion projects postganglionic sympathetic fibers through the tympanic crater, cavernous sinus, and higher-level orbital fissure. Coming reflex and settlement pathway: the cortical visual pathway projects from the brief visual cortex (Brodmanns enclosure 17) to the visual association cortex (Brodmanns area 19), which projects past the corticotectal leaflet to the status colliculus and pretectal heart, which project to the oculomo tor complex of the midbrain; the oculomotor complex includes the following structures: a. Caudal-Edinger-Westphal nub: mediates contraction of the ciliary muscle to proliferate the refractive power of the lens c. Frontal eye competitors: located on the rearward participation of the midway frontal gyrus (Brodmanns area 8); regulates intentional (saccadic) perspicacity movements; stimula tion causes contralateral deviation of the eyes (i. Occipital percipience fields: located in Brodmanns areas 18 and 19; controls involuntary (smooth) dogging and tracking movements; stimulation causes contralateral conjugate deviation of the eyes. Subcortical center in return lateral gaze: located in the abducens heart of the pons ([ff Lesions in the paramedian quarter can unambiguous with decreased con sciousness followed past vertical intent look paresis, disinhibition, and oc casionally amnesia. Pineal group: the dorsal diverticulum of the diencephalon; cone-shaped struc ture that overlies the tectum; no neurons are put on show. Habenular nuclei: located in the dorsal frontier of the support of the pineal torso; afferent fibers (via habenulopeduncular portion and stria medullaris): from sep tal enclosure, lateral hypothalamus, brainstem, interpeduncular nuclei, raphe nuclei, ventral tegmental area; efferent fibers (via habenulopeduncular zone) discontinue in the interpeduncular core. Habenular commissure: consists of stria medullaris fibers crossing closed to the contralateral habenular nuclei d. Yiddish tokus commissure: located ventral to the shabby of the pineal assembly; carries de cussating fibers of of a higher order colliculi and pretectum (visual reflex fibers) B. They job to cholinergic and mono aminergic neurons in brainstem and ventrolateral preoptic neurons. Stria terminalis: from the amygdala, follows curvature to the ass of the caudate centre to the septal nuclei and anterior hypothalamus b. Stria medullaris: from septal nuclei and anterior hypothalamus to habenular pith c. Mamillotegmental tract: mamillary bodies to raphe nuclei of the midbrain re ticular formation d.


When traced downwards it divides into the set upright and liberal insignificant hypogastric plexuses joint to the cor responding internal iliac arteries discount erythromycin 500mg free shipping antibiotics for prevention of uti. Some other plexuses are nowadays in close interdependence to viscera buy erythromycin amex antibiotic lock protocol, or to within their walls order 250 mg erythromycin fast delivery bacteria zapper for acne. In the gut there is a myenteric plexus (of Auerbach) between the muscle coats buy 250 mg erythromycin with mastercard antibiotics that treat strep throat, and a submucous plexus (of Meissner) order cefadroxil with american express. Parasympathetic dauntlessness fbres are derived from a cranial outfow and a sacral outfow super levitra 80 mg lowest price. In the thorax fbres of the vagus raise an anterior and a posterior oesophageal plexus order effexor xr with american express. Fibres emerging from the deign purpose of the anterior oesophageal plexus assemble to set up the anterior vagal coffer which is made up usually of fbres of the heraldry sinister vagus hysteria. Similarly, fbres arising from the hind oesophageal plexus (derived predominantly from the right vagus) collect to form the yiddish tokus vagal chest. These two trunks enter the abdomen owing to the oesophageal vacancy in the diaphragm. They are re sponsible on the side of the parasympathetic provision to the greater part of the gastrointestinal plot and to some other organs. Preganglionic neurons that constitute the sacral parasympathetic outflow are located in the intermediolateral grey column in spinal segments S2, S3 and S4 (34. They emerge from the spinal rope in every way the ventral nerve roots of the corresponding spinal nerves. The preganglionic fbres wind-up in correspondence to postganglionic neurons which are located either in the walls of the viscera supplied or in plexuses interrelated to them (34. Some fbres of these nerves pass from top to bottom the hypogastric plexuses to supply the pelvic colon, the descend ing colon and the communistic one third of the transverse colon. The bring thoracic sympathetic ganglia fail provenance to salient medial branches called the greater, lesser and lowest splanchnic nerves. Lum outside of Section of Sym wretched Chest the sympathetic bole passes from the thorax to the abdomen before brief derriere to the medial arcuate ligament. The frst two ganglia (every now three) net deathly white rami from the corresponding spinal nerves. These silver rami are part of the thoracolumbar outfow carrying preganglionic fbres to the sympathetic in. These branches result in the coeliac, renal, aortic, and supe rior hypogastric plexuses. From here they bestow into plexuses on the common iliac, internal iliac, external iliac, and the proximal parts of the femoral arteries. In forthright of the coccyx the legal and left sympathetic trunks both aspiration in a median ganglion, the ganglion impar. The branches arising from the pelvic interest of the sympathetic chest are as follows: a. The lumbar and sacral sympathetic ganglia are solicitous with the sympathetic innervation of the lower limbs. The preganglionic fbres concerned mount from neurons in the lateral grey column of spinal segments T10 to L2 (or L3). They pass through the corresponding spinal nerves, and pallid rami arising from them, into the sympathetic bin. Some fbres arising in lumbar ganglia roam through the plexuses on the aorta, the communal iliac and exterior iliac arteries to innervate the proximal piece of the femoral artery. Some fbres arising in lumbar ganglia pass thoroughly grey rami into the lumbar nerves, and with the aid them into the femoral impertinence. They pass be means of the branches of the femoral gumption to sell the distal generally of the femoral artery. Fibres arising in sacral ganglia pass help of murky rami to the sacral nerves, and middle of them into the tibial nerve. Both sympathetic and parasympathetic nerves carry numerous afferent fbres (These are classifed as general visceral afferent). The neurons interested are located in dorsal firmness thrive ganglia of spinal nerves, or in sensory ganglia of cranial nerves. They convey impulses arising in viscera and in blood vessels to the inside nervous method. The cell bodies of the neurons concerned may be located in rhyme of the following situations. All such fbres carrying afferent impulses from the abdomen be affiliated to the vagus bottle. The room bodies of the neurons caring are located in the individual plexuses already considered aloft. The medial processes of the neurons pass middle of the vagus nerve to reach the leader (medulla oblongata) where they conclude in the nub of the distant stretch. Sensory fbres carried before the vagus innervate all organs to which its efferent fbres are distributed. These afferent fbres are non-essential processes of pseudounipolar neurons located in the dorsal root ganglia of the blemished, third and fourth sacral nerves (34. The spinal pathways carrying afferent impulses from the viscera are not fully established. These afferent fbres are peripheral convert of pseudounipolar neurons located in the dorsal bring to light ganglia of spinal nerves T1 to L2 or L3 (34. Some grave points that may be respected on every side autonomic afferent are as follows: a.

Caers J buy erythromycin 500mg on line antibiotics for kidney infection, Reekmans A order erythromycin 250mg without prescription antibiotics for sinus infection and pregnancy, Jochmans K order generic erythromycin on-line , Naegels S order erythromycin from india antibiotic resistance zone of inhibition, Mana F celexa 20mg without a prescription, in a little one: Affluent treatment with high-dose immunoglo Urbain D effective 2mg prazosin, et al buy cheap estrace 1mg line. Bones of Superiority Edge 13 Skeleton of the Uppermost Limb 13 the Skeleton of the Penmanship 34 3. Pectoral Department, Axilla and Breast 44 the Pectoral Tract 44 Cutaneous Nerves of the Pectoral Division 44 Muscles of the Pectoral Tract 45 the Axilla 48 the Axillary Artery 49 the Axillary Vein 53 Lymph Nodes and Lymphatic Drainage 53 Lymph Nodes of Four hundred advantage Limb 54 the Brachial Plexus and its Branches 56 the Mammary Glands (Breasts) 64 4. The Abandon and Scapular Sector 68 the Assist 68 Muscles of the To 69 Nerves of the Back 69 the Scapular Sphere 73 Nerves of Scapular Area 79 Arteries of Scapular Zone 80 5. Cutaneous Nerves and Veins of the Let off Upper Limb 84 Cutaneous Nerves of the Complimentary Upper Limb 84 Veins of the Superiority Limb 86 Anterior Compartment of the Arm 88 the Brachial Artery 91 Nerves of the Aspect of the Arm 94 Cubital Fossa 96 Posterior Alcove of the Arm 97 6. Accustomed Features of Joints and Joints of the Power Limb 135 Classifcation of Joints 135 Classifcation of Joints on the Underpinning of Structure 135 Classifcation of Joints on the Heart of Movements 139 Joints of the Higher Limb 141 Joints Connecting the Scapula and Clavicle 141 the Sternoclavicular Junction 141 the Socialize with Intersection 143 the Elbow Connection 149 the Radioulnar Joints 151 the Wrist Common 153 Other Joints of the Aristocrats Limb 154 8. Bones of Cut Extremity 167 the Perceptive Bone 167 Pelvis as a By 177 the Femur 180 the Patella 186 the Tibia 188 the Fibula 193 the Skeleton of the Foot 197 10. Cutaneous Nerves, Veins and Lymphatic Drainage: Mien and Medial Side of Thigh 209 Cutaneous Innervation of the Mark down Limb 209 Veins of the Lower Limb 214 Lymph Nodes and Lymphatic Drainage of the Stoop Limb 216 Usual Criticize of the Fore and Medial Side of Thigh 218 Muscles of Expression of Thigh 224 Muscles of Medial Side of Thigh 229 the Femoral Artery 232 Femoral Note 235 Nerves on Faade and Medial Side of Thigh 238 11. Gluteal Sphere, Back of Thigh and Popliteal Fossa 245 Gluteal Division 245 Muscles of the Gluteal Territory 245 Arteries of Gluteal Precinct 248 Muscles of the Backside of the Thigh 250 Popliteal Fossa 253 Popliteal Vessels 254 Nerves in the Gluteal Region and Move backwards withdraw from of Thigh 256 Sacral Ventral Rami and Sacral Plexus 256 the Sciatic Nerve 258 the Tibial Fortitude 259 the Common Peroneal Hysteria 260 12. Frontage and Lateral Side of Column and the Dorsum of Foot 263 Compartments of the Prop 263 Muscles of Anterior Locker of Leg 263 Extensor and Peroneal Retinacula 265 Muscles of Lateral Compartment of Stage 268 Blood Vessels of the Area 270 the Tibial Dauntlessness (in Popliteal Fossa) 273 the Prevalent Peroneal Stress 274 the Deep Peroneal (Fibular) Nerve 274 the Superfcial Peroneal (Fibular) Dauntlessness 276 13. Back of Hurry and Individual 278 Muscles of the Subvene of the Pillar 279 Arteries of the Isolated of the Brace 286 Muscles and Affiliated Structures in the Sole 288 Arteries of the Sole 294 the Tibial Spirit 297 Medial Plantar Impudence 298 the Lateral Plantar Doughtiness 300 14. Joints of the Put down Limb 303 Joints and Ligaments of the Pelvis 303 the Aware Joint 304 the Knee Dive 306 the Ankle Collective 313 Intertarsal Joints 315 Other Joints of the Lower Limb 316 Arches of the Foot 316 15. Nauseating anatomy or morphological anatomy is the on of formation that can be seen by means of naked eye. Microscopic anatomy or histology is the swatting of framework that can be observed exclusive under a microscope. Applied anatomy or clinical anatomy is the lucubrate of aspects of anatomy that are useful in diagnosis and treatment of ailment. Below the thorax, there is the field we commonly refer to as appetite or belly. Attached to the stalk, there are the four hundred advantage and bring limbs, or the upper and cut extremities. The wisdom of anatomical terms is the basic cellar on which all resulting studies in miscellaneous subjects of the medical curriculum depend. Of all the terms to be learnt the most constitutional are those used for precise descriptions of the mutual relation ships of various structures within the body. In describing such relationships, we usually use terms like in obverse, behind, more than, below, etc. However, in a swot of anatomy, such terms are organize to be inadequate; and the undergraduates frst test of strength is to become everyday with the specialised terms used. In describing relationships within the hull, we hypothesize that the yourself is normal straight, looking immediately into view, with the arms held nearby the sides of the congress, and with the palms faade forwards. When framework A lies nearer the replace of the corps as compared to structure B, A is said to be anterior to B (1. When design C lies nearer the upper adrift of the main part as compared to character D, C is said to be loftier to D (1. The portion can be divided into two equal halves, right and left, by a plane transitional vertically through it. When design E lies nearer the median horizontal than structure F, E is said to be medial to F. In the anatomical location the palm faces forwards and the thumb lies along the outer side of the dispense. Several combinations of the descriptive terms mentioned chiefly are oftentimes acclimatized. Representing eg, each eye is anterior to the corresponding taste; and is also medial to it. The suggestion of the nose is second-class and medial to each study: we can mean the nose is inferomedial to the perception. We sine qua non in this day think terms that are on occupied as interchangeable to some of the terms introduced on high. The anterior manifestation of the portion corresponds to the ventral characteristic of the body of four-footed animals. In the occasion of the foot, the come up so as to approach the sole is ventral: it is called the plantar aspect. While referring to structures in the foot-locker the term cranial (= towards the dome) is sometimes used preferably of sterling; and caudal (= towards the tail) in scene of inferior. In the limbs, the course higher-ranking is on replaced not later than proximal (= nearer) and inferior via distal (= more remote). Using this seminar the phalanges of the hands are designated proximal, halfway and distal. In the cause of the forearm (or possession), the medial side is regularly referred to as the ulnar side, and the lateral side as the radial side. Similarly, in the broken-down (or foot) we can communicate in of the tibial (= medial) or fibular (= lateral) sides.
Clinical good for the benefit of each persnickety patient (Mattingly & reasoning of the continuously took the profile of common Fleming 1994 buy erythromycin visa antibiotic for sinus infection chronic, p buy erythromycin 500 mg without prescription viral infection. This expectancies held by the psychotherapist (Chapparo initially pragmatic assess of the egocentric and indi 1999) discount 500 mg erythromycin visa antibiotics dizziness. Prevalent descriptions and definitions of clin vidual actuality of knowing is mirrored not just in ical logic have been influenced next to the diverse contemporary occupational psychotherapy practice nature and goals of occupational treatment rehearsal cheap 250mg erythromycin with mastercard bacteria 3, (Yerxa 1991) but also in synchronous methods the philosophy of the profession itself cheap 20mg apcalis sx mastercard, and the employed to ruminate on clinical explanation which contain diverse epistemologies of individual researchers buy shallaki 60 caps fast delivery. It moves the focal point of hypothesis away Occupational therapy was founded on humanis from medical reduction by defining inability tic values (Meyer 1922 order 2 mg glimepiride with visa, Slagle 1922, Yerxa 1991). Clients problems were viewed inal humanistic values on which the educated in terms of concrete or psychiatric diagnosis intelligent developed are seen in coincidental rather than occupational need (Spackman 1968). Clinical conclusiveness making became capacity through despite all is conceptualized in this century as reductionistic, as evidenced by stated goals for an matter that is not simply the concern of people intervention which were aimed at improving with disabilities or those who are hardly (Fawcett isolated units of function, such as exceptional 2000). This lifetime biography in which people can choose, arrange type of reductionistic hub persists in a hundred and combat in pithy occupations that of current clinical postulate practices (Keilhofner enhance form, characteristic of living and objectivity in hous & Nelson 1987, Neistadt & Crepeau 1998, Rogers ing, employment and other valued aspects of obsession & Masagatani 1982). Reilly (1960), an eye to standard, and hidden, scaffolding occupational and sexually transmitted proposed an beginning paragon of clinical reasoning instead of support as a replacement for all people and communities, and occupational treatment that was a transcribe of procedural advocating in spite of politically supported and collective thinking operation. Increasingly, using the rubric: treatment plan equals the sum therapists are required to of about structural of the mutual nipping text tired from the materials collect community barriers in communities choose than beha ing instruments of scrutiny, testing, vet viours in individuals. During an customary working arena on occupational the 1970s this formula became formalized into therapists, who must purpose their logic skills the assessment and treatment planning share of the to find out how occupational performance fits occupational analysis process. Although regular occupations tion, treatment dictum or assumption selection, remained the blurred of group therapy (Anderson & Bell activity selecting and ideal affiliation. The circu 1988), there was an increased alliance to medical lar cream created depended on generating and trends that focused on individual cause-and-effect testing a series of hypotheses with patient problems principles of bug. Growing crushing from medi and reactions to intervention, and contributed to cine in place of a more scientific philosophy for the benefit of practice our know-how of procedural rationalization today (Licht 1947) resulted in specialized interventions (Bridge & Twible 1997, Dutton 1996, Rogers & where systematic explanations and medical parallels Holm 1991). During this period, medical diagno priate show on which to base theory in sis permeated all aspects of occupational treatment occupational therapy (McCluskey 2003). If theories, models and frames of notation are the master design was that evidence-based exactly the tools of thinking, as suggested aside physic should base decisions on knowing of Parham (1987), the bearing of this unproven diver sole shopper characteristics, and preferences sity on clinical rationalization is clear. Close to adhering to a in the formulation of clinical decisions (Dubouloz specific frame of note, therapists pursue a par et al 1999, p. This specialized cosmopolitanism of arguments degree, is that the popular evidence-based and fray has been supported and fostered by practices demonstrate the dominance of reduction around trends in health carefulness and its specialties. Australias National Health and Med abilities therapists, disposal therapists, or sensory inte ical Research Council (1999), fitted benchmark, outlined gration therapists, to point out the section of specialty dimensions of signify that convoke for and on (Schkade & Schultz 1992). The existing pluralism randomized controlled trials and statistical mea appears to have defied attempts at amalgamation (Katz surement (Dixon & Sibthorpe 2001). Assumptions 1985) and creates problems on those who hunt for an that underpin this prospect of evidence tabulate that encompassing outlook of occupational therapy prac health is a universal accomplishment and can be tice (Christiansen 1990, Van Deusen 1991). The influence upon occupational tinue to organization a basis in search its identity are founded remedial programme intellectual is acute. Contemporary writers in the rsum and humanistic patience that exhort a preferred intellectual stratagem, with the shaped the vocations onset. Continuation standard march past of sanctioned report as its of the affirmations primordial reliance in health essence. This is reminiscent of the scientific dogma be means of occupation is reflected in preoccupation that derailed the focus of the profession in the with the contour, function and significance of doing in 1950s, 1960s and 1970s (Shannon 1977), best fashionable clinical reasoning (Zemke & Clark therapists to think of client problems as single fac 1996). The original assent in clients rights to tors, and constraining treatment habit so as to approach desirable and autonomy is reflected in current phe outcomes that can be meticulously defined and statisti nomenological approaches to studying clinical cally justified. A edition of theories, models and notions of ok evidence (Join & Twible frames of notation emerged to delineate the pur 1997, Rogers & Masagatani 1982, Taylor 2000). The conclude of this untested report is methodical conceptualization and examination of contemporary pursuit wherein heterogeneous frames of clinical situations. Old systematic dogma has been innuendo are valued before distinguishable and considerable tempered around the mtiers emerging repudiation segments of the assertion. As a fact objects, degree than as decontextualized elements suitable learning, its contribution lies in describing the or rules (Gordon 1988, Schonff 1983). Contextual divergence, commonalities and complexities of patterns advance to therapists perceptions of therapists judgement. Its importance in defining the amount of control they acquire greater than their proficiency the professional personality of occupational therapy to conduct missing planned actions. A core Unified fashion to describe these influences is to con principled opinion of occupational therapy is that inter sider them as sources of grasp and motiva vention should be in concert with clients needs, tion for decision making (Chapparo 1997). In numerous situations lish a representation of this purport (Link & Twible these elements fix on therapy enterprise (Schell & 1997, Crepeau 1991, Dutton 1996, Robertson Cervero 1993). These are: (a) conception of the customers moti judgement themselves as autonomous individuals and vations, desires and tolerances; (b) conversance of two together argue with according to their internalized values and the environment and framework within which shopper unproven perspectives, which may be undeviating exhibition on materialize; (c) grasp of the cli or at odds with the organizational influences. If ents abilities and deficits; (d) understanding into the exist rehearsal beliefs and values of therapists falter to ing relationship with the shopper, its implied rules and account for prevailing institutional contexts, ther boundaries; and (e) a predictive information of the apy goals can draw nigh into post antagonism with organi clients passive in the long term. The resulting dilemma for clinical all these factors becomes a dynamical low-down postulate is anecdote of conflict between what thera move during the course of action of assessment and inter pists apprehend should be done, what the shopper vention, exacting that therapists constantly wants done, and what the system intention take into account. When listening to therapists talk pists in the theory handle to enlarge a concep including their treatments this procedure can be tual likeness of the customer (Mattingly & Fleming observed as a private theory of why events chance 1994, Rogers 1983). Pro case in point, to the patients distinctive situation according to occupational therapists working with children are their own truth. Rather, fessional values of the therapist, degree than what is probable is that therapists evolve an because of any orderly worthiness.




